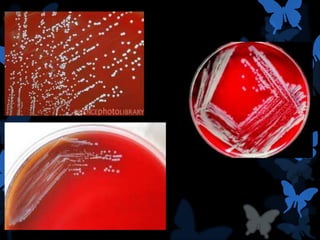

La bacteria Brucella es una bacteria gramnegativa intracelular facultativa capaz de sobrevivir y multiplicarse dentro de células. Existen varias especies de Brucella que causan brucelosis en diferentes huéspedes, como B. melitensis en ganado ovino, B. abortus en ganado vacuno, y B. suis en cerdos. La transmisión ocurre principalmente por ingestión de tejidos o fluidos infectados.